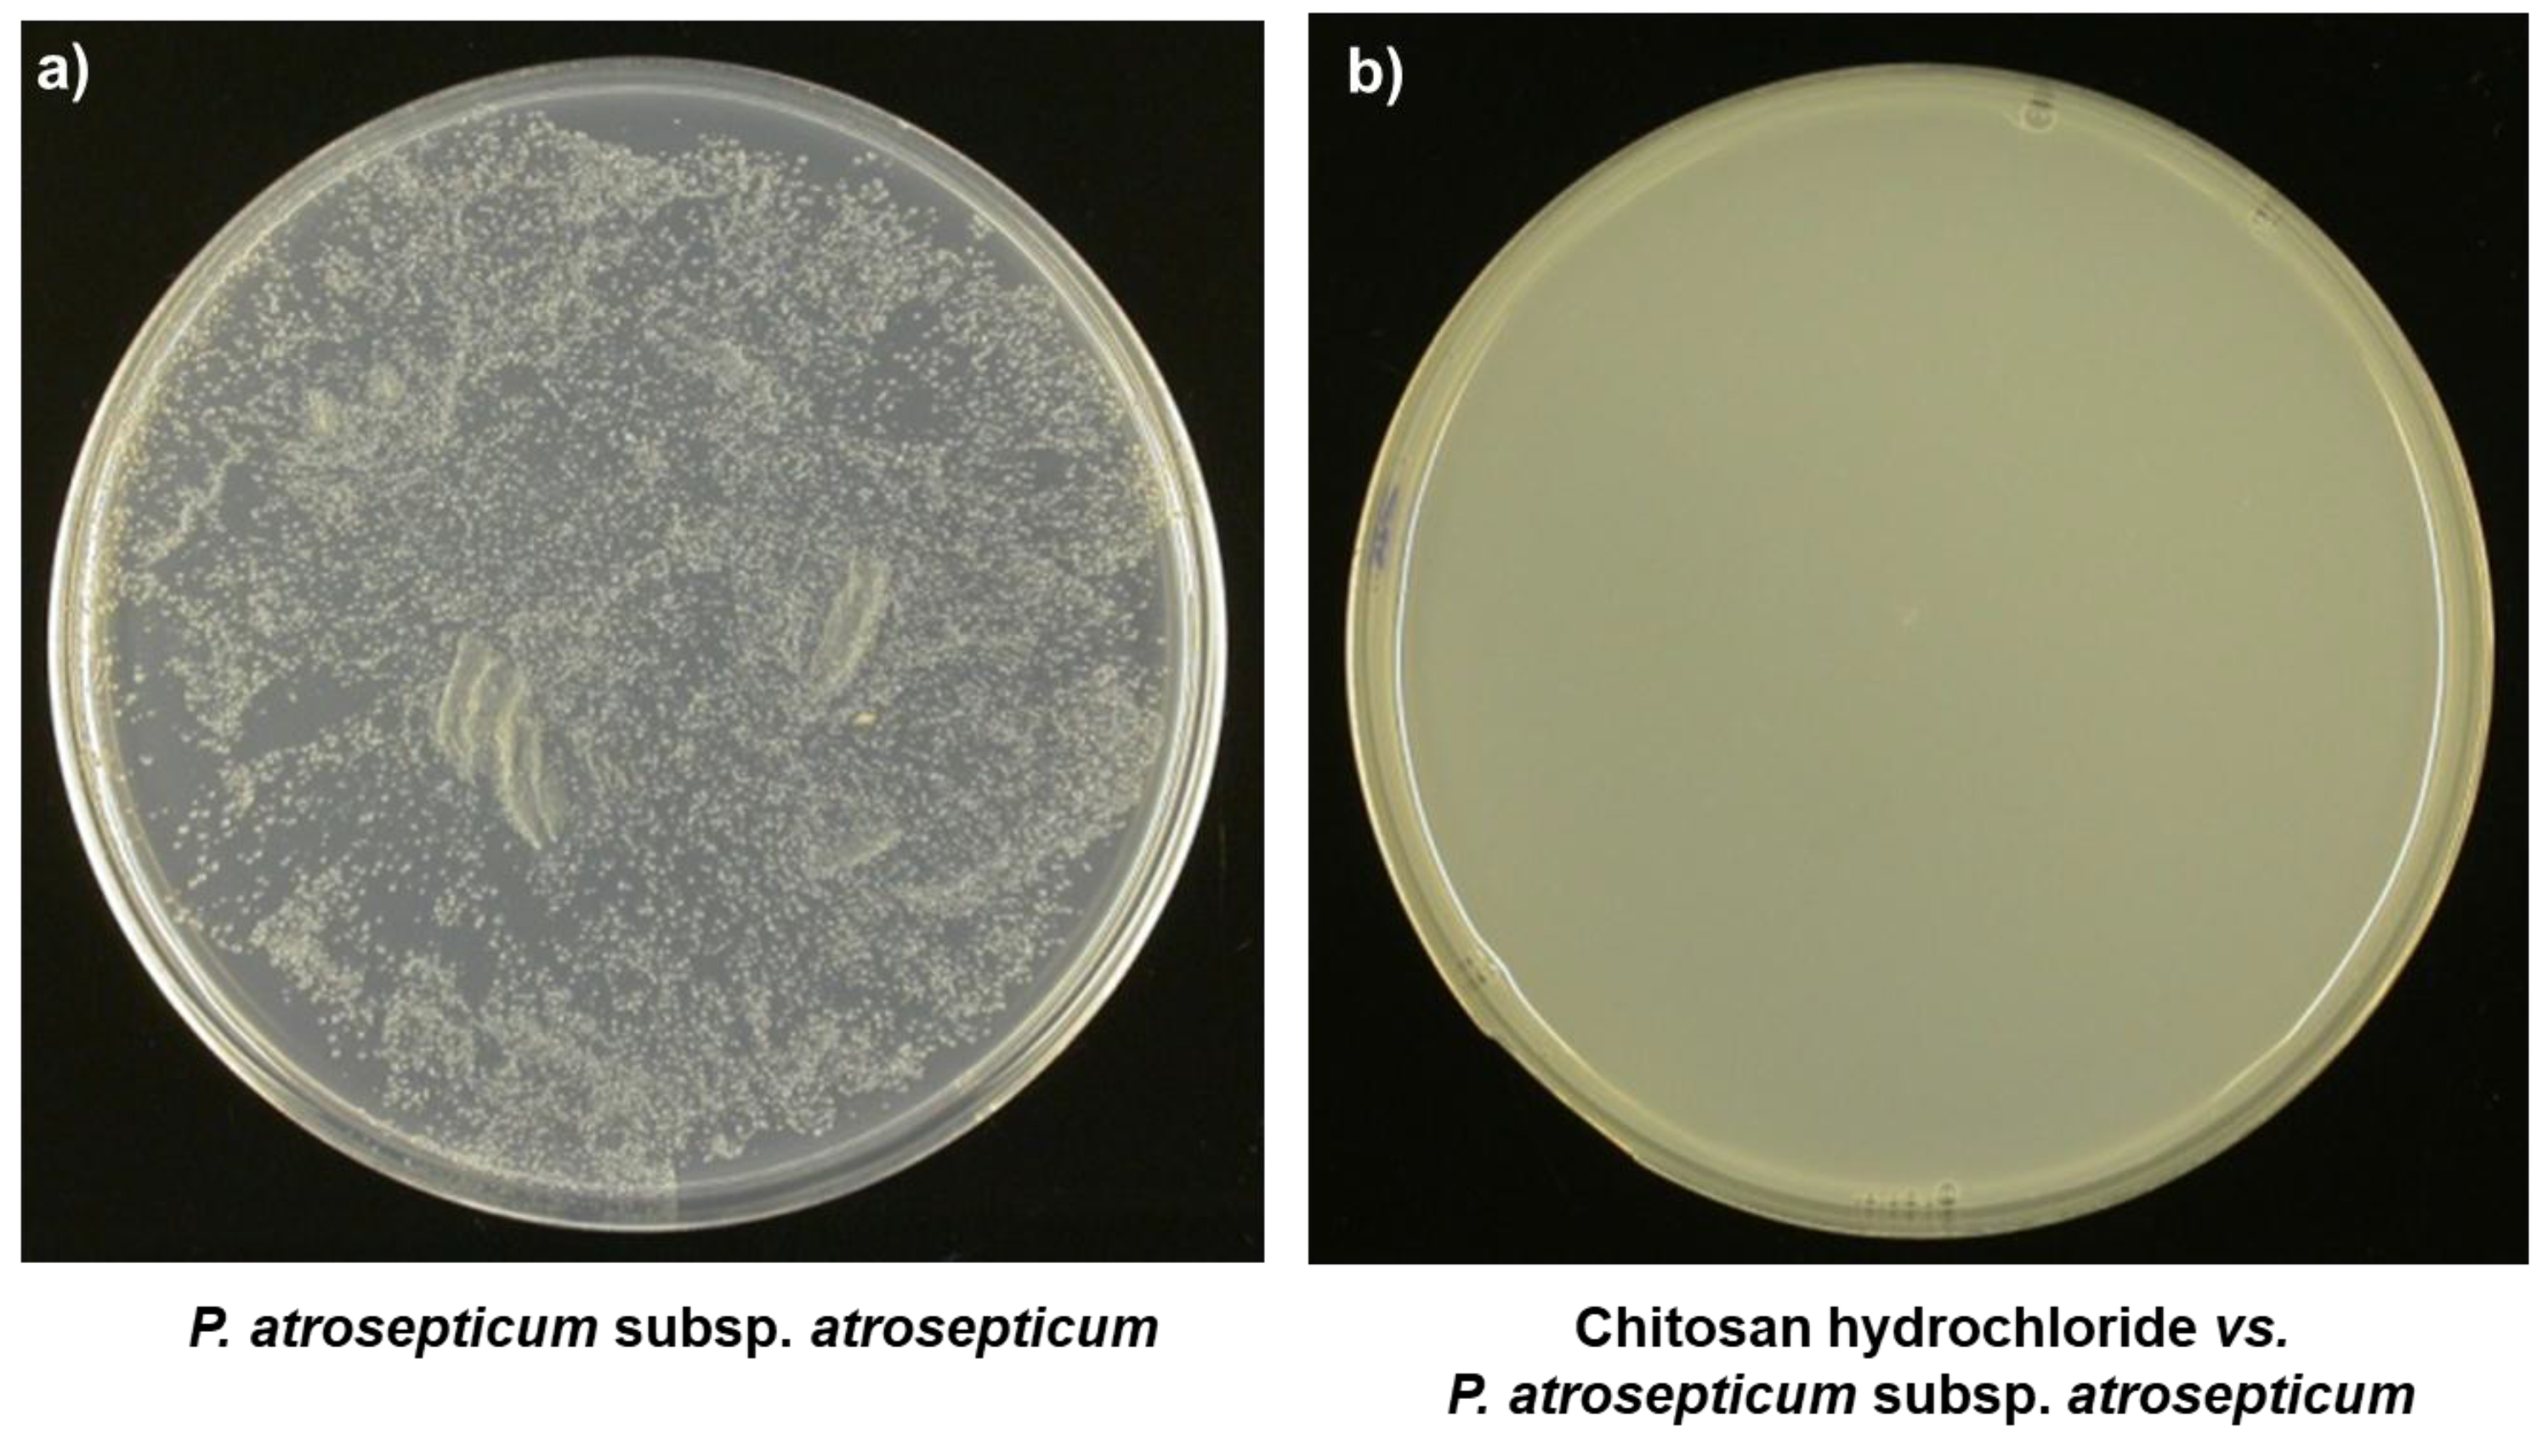

Effective Postharvest Preservation of Kiwifruit and Romaine Lettuce with a Chitosan Hydrochloride Coating
Abstract
1. Introduction
2. Materials and Methods
2.1. Materials
2.2. Preparation and Characterization of Film Coating-Forming Solution
2.3. In Vitro Antimicrobial Assays
2.4. Coating Application and in Vivo Tests on Kiwifruits and Lettuce
3. Results and Discussion
3.1. Morphological, Chemical, and Thermal Properties of Polymer Pellet and Chitosan-Based Film Coating
3.2. Antimicrobial In Vitro Activity of Chitosan Hydrochloride
3.3. Antimicrobial Activity on Stored Fruits and Vegetables: In Vivo Assays
4. Conclusions
Author Contributions
Conflicts of Interest
References
- Lugtenberg, B.; Rozen, D.E.; Kamilova, F. Wars between microbes on roots and fruits. F1000Research 2017, 6, 343. [Google Scholar] [CrossRef] [PubMed]
- Gastavsson, J.; Cederberg, C.; Sonesson, U. Global Food Losses and Food Waste; Food and Agriculture Organization (FAO) of the United Nations: Rome, Italy, 2011. [Google Scholar]
- Eckert, J.W.; Ogawa, J.M. The chemical control of postharvest diseases: Deciduous fruit, berries, vegetables and root/tuber crops. Annu. Rev. Phytopathol. 1988, 26, 433–469. [Google Scholar] [CrossRef]
- Spotts, R.A.; Cervantes, L.A. Populations, pathogenicity, and benomyl resistance of Botrytis spp., Penicillium spp., and Mucor piriformis in packinghouses. Plant Dis. 1986, 70, 106–108. [Google Scholar] [CrossRef]
- Wilson, C.L.; Pusey, P.L. Potential for biological control of postharvest plant diseases. Plant Dis. 1985, 69, 375–378. [Google Scholar] [CrossRef]
- Wilson, C.L.; Wisniewski, M.E. Biological control of postharvest diseases of fruits and vegetables: An emerging technolygy. Annu. Rev. Phytopathol. 1989, 27, 425–441. [Google Scholar] [CrossRef]
- Sharma, R.R.; Singh, D.; Singh, R. Biological control of postharvest diseases of fruits and vegetables by microbial antagonists: A review. Biol. Control 2009, 50, 205–221. [Google Scholar] [CrossRef]
- Yang, W.; Fortunati, E.; Dominici, F.; Giovanale, G.; Mazzaglia, A.; Balestra, G.M.; Kenny, J.M.; Puglia, D. Synergic effect of cellulose and lignin nanostructures in PLA based systems for food antibacterial packaging. Eur. Polym. J. 2016, 79, 1–12. [Google Scholar] [CrossRef]
- Mazzaglia, A.; Fortunati, E.; Kenny, J.K.; Torre, L.; Balestra, G.M. Nanomaterials in Plant Protection. In Nanotechnology in Agriculture and Food Science; Axelos, M.A.V., Van de Voorde, M., Eds.; Wiley-VCH Verlag GmbH & Co. KGaA: Weinheim, Germany, 2017; pp. 115–134. [Google Scholar]
- Fortunati, E.; Benincasa, P.; Balestra, G.M.; Luzi, F.; Mazzaglia, A.; Del Buono, D.; Puglia, D.; Torre, L. Revalorization of barley straw and husk as precursors for cellulose nanocrystals extraction and their effect on PVA_CH nanocomposites. Ind. Crops Prod. 2016, 92, 201–217. [Google Scholar] [CrossRef]
- Luzi, F.; Fortunati, E.; Giovanale, G.; Mazzaglia, A.; Torre, L.; Balestra, G.M. Cellulose nanocrystals from Actinidia deliciosa pruning residues combined with carvacrol in PVA_CH films with antioxidant/antimicrobial properties for packaging applications. Int. J. Biol. Macromol. 2017, 104, 43–55. [Google Scholar] [CrossRef] [PubMed]
- Badawy, M.E.I.; Rabea, E.I. Potential of the biopolymer chitosan with different molecular weights to control postharvest gray mold of tomato fruit. Postharvest Biol. Technol. 2009, 51, 110–117. [Google Scholar] [CrossRef]
- Davila-Avina, J.E.J.; Villa-Rodríguez, J.; Cruz-Valenzuela, R.; Rodríguez-Armenta, M.; Espino-Díaz, M.; Ayala-Zavala, J.F.; Gonzalez-Aguilar, G. Effect of edible coatings, storage time and maturity stage on overall quality of tomato fruits. Am. J. Agric. Biol. Sci. 2011, 6, 162–171. [Google Scholar] [CrossRef]
- Perdones, A.; Escriche, I.; Chiralt, A.; Vargas, M. Effect of chitosan–lemon essential oil coatings on volatile profile of strawberries during storage. Food Chem. 2016, 197, 979–986. [Google Scholar] [CrossRef] [PubMed]
- Lee, S.Y.; Lee, S.J.; Choi, D.S.; Hur, S.J. Current topics in active and intelligent food packaging for preservation of fresh foods. J. Sci. Food Agric. 2015, 95, 2799–2810. [Google Scholar] [CrossRef] [PubMed]
- Romanazzi, G.; Feliziani, E.; Santini, M.; Landi, L. Effectiveness of postharvest treatment with chitosan and other resistance inducers in the control of storage decay of strawberry. Postharvest Biol. Technol. 2013, 75, 24–27. [Google Scholar] [CrossRef]
- Jongsri, P.; Wangsomboondee, T.; Rojsitthisak, P.; Seraypheap, K. Effect of molecular weights of chitosan coating on postharvest quality and physicochemical characteristics of mango fruit. LWT Food Sci. Technol. 2016, 73, 28–36. [Google Scholar] [CrossRef]
- Dhall, R.K. Advances in edible coatings for fresh fruits and vegetables: A review. Crit. Rev. Food Sci. Nutr. 2013, 53, 435–450. [Google Scholar] [CrossRef] [PubMed]
- Falguera, V.; Quintero, J.P.; Jimenez, A.; Munoz, J.A.; Ibarza, A. Edible films and coatings: Structures, active functions and trends in their use. Trends Food Sci. Technol. 2011, 22, 292–303. [Google Scholar] [CrossRef]
- Kanmani, P.; Rhim, J.W. Antimicrobial and physical-mechanical properties of agar-based films incorporated with grapefruit seed extract. Carbohydr. Polym. 2014, 102, 708–716. [Google Scholar] [CrossRef] [PubMed]
- Maswada, H.F.; Abdallah, S.A. In vitro activity of three geophytic plant extracts against three post-harvest pathogenic fungi. Pak. J. Biol. Sci. 2013, 23, 1698–1705. [Google Scholar] [CrossRef]
- Silva-Weiss, A.; Bifani, V.; Ihl, M.; Sobral, P.J.A.; Gomez-Guillen, M.C. Polyphenol-rich extract from murta leaves on rheological properties of film-forming solutions based on different hydrocolloid blends. J. Food Eng. 2014, 140, 28–38. [Google Scholar] [CrossRef]
- Review Report for the Basic Substance Chitosan Hydrochloride Finalised in the Standing Committee on the Food Chain and Animal Health at its meeting on 20 March 2014—In View of the Approval of Chitosan Hydrochloride as Basic substance in Accordance with Regulation (EC) No 1107/2009; European Commission: Brussels, Belgium, 2014.
- Carlson, R.P.; Taffs, R.; Davison, W.M.; Stewart, P.S. Anti-biofilm properties of chitosan coated surfaces. J. Biomater. Sci. Polym. Ed. 2008, 19, 1035–1046. [Google Scholar] [CrossRef] [PubMed]
- Kumar, R.M.N.V. A review of chitin and chitosan applications. React. Funct. Polym. 2000, 46, 1–27. [Google Scholar] [CrossRef]
- Devlieghere, F.; Vermeulen, A.; Debevere, J. Chitosan: Antimicrobial activity, interactions with food components and applicability as a coating on fruit and vegetables. Food Microbiol. 2004, 21, 703–714. [Google Scholar] [CrossRef]
- Tharanathan, R.N.; Kittur, F.S. Chitin—The undisputed biomolecule of great potential. Crit. Rev. Food Sci. Nutr. 2003, 43, 61–87. [Google Scholar] [CrossRef] [PubMed]
- Benhabiles, M.S.; Salah, R.; Lounici, H.; Drouiche, N.; Goosen, M.F.A.; Mameri, N. Antibacterial activity of chitin, chitosan and its oligomers prepared fromshrimp shell waste. Food Hydrocoll. 2012, 29, 48–56. [Google Scholar] [CrossRef]
- Yen, M.T.; Tseng, Y.H.; Li, R.C.; Mau, J.L. Antioxidant properties of fungal chitosan from shiitake stipes. LWT Food Sci. Technol. 2007, 40, 255–261. [Google Scholar] [CrossRef]
- Davidson, A. The Oxford Companion to Food; Oxford University Press: Oxford, UK, 1999. [Google Scholar]
- Elad, Y.; Williamson, B.; Tudzinski, P.; Delen, N. Botrytis: Biology, Pathology and Control; Springer: Berlin, Germany, 2007; p. 403. [Google Scholar]
- Ma, B.; Hibbing, M.E.; Kim, H.S.; Reedy, R.M.; Yedidia, I.; Breuer, J.; Breuer, J.; Glasner, J.D.; Perna, N.T.; Kelman, A.; et al. Host range and molecular phylogenies of the soft rot enterobacterial genera pectobacterium and dickeya. Phytopathology 2007, 97, 1150–1163. [Google Scholar] [CrossRef] [PubMed]
- No, H.K.; Meyers, S.P.; Prinyawiwatkul, W.; Xu, Z. Applications of chitosan for improvement of quality and shelf life of food: A Review. J. Food Sci. Technol. 2007, 72, 87–100. [Google Scholar] [CrossRef] [PubMed]
- Bonilla, J.; Fortunati, E.; Vargas, M.; Chiralt, A.; Kenny, J.M. Effects of chitosan on the physicochemical and antimicrobial properties of PLA films. J. Food Eng. 2013, 119, 236–243. [Google Scholar] [CrossRef]
- Lawrie, G.; Keen, I.; Drew, B.; Chandler-Temple, A.; Rintoul, L.; Fredericks, P.; Grøndahl, L. Interactions between Alginate and Chitosan Biopolymers Characterized Using FTIR and XPS. Biomacromolecules 2007, 8, 2533–2541. [Google Scholar] [CrossRef] [PubMed]
- Bonilla, J.; Fortunati, E.; Atarés, L.; Chiralt, A.; Kenny, J.M. Physical, structural and antimicrobial properties of poly vinyl alcohol–chitosan biodegradable films. Food Hydrocoll. 2014, 35, 463–470. [Google Scholar] [CrossRef]
- Chen, C.H.; Wang, F.Y.; Mao, C.F.; Liao, W.T.; Hsieh, C.D. Studies of chitosan: II. Preparation and characterization of chitosan/poly(vinyl alcohol)/gelatin ternary blend films. Int. J. Biol. Macromol. 2008, 43, 37–42. [Google Scholar] [CrossRef] [PubMed]
- Quattrucci, A.; Ovidi, E.; Tiezzi, A.; Vinciguerra, V.; Balestra, G.M. Biological control of tomato bacterial speck using Punica granatum fruit peel extract. Crop Prot. 2013, 46, 18–22. [Google Scholar] [CrossRef]
- Fortunati, E.; Rescignano, N.; Botticella, E.; La Fiandra, D.; Renzi, M.; Mazzaglia, A.; Balestra, G.M. Effect of poly(DL-lactide-co-glycolide) nanoparticles or cellulose nanocrystals-based formulations on Pseudomonas syringae pv. tomato (Pst) and tomato plant development. J. Plant Dis. Prot. 2016, 123, 301–310. [Google Scholar] [CrossRef]
- Rossetti, A.; Mazzaglia, A.; Muganu, M.; Paolocci, M.; Sguizzato, M.; Esposito, E.; Cortesi, R.; Balestra, G.M. Microparticles containing gallic and ellagic acids for the biological control of bacterial diseases of kiwifruit plants. J. Plant Dis. Prot. 2017, 124, 269–278. [Google Scholar] [CrossRef]
- Michailides, T.J.; Morgan, D.P. New technique predicts gray mold in stored kiwifruit. Calif. Agric. 1996, 50, 34–40. [Google Scholar] [CrossRef][Green Version]
- El Gaouth, A.; Arul, J.; Grenier, J.; Asselin, A. Antifungal activity of chitosan on two postharvest pathogens of strawberry fruits. Phytopathology 1992, 82, 398–402. [Google Scholar] [CrossRef]
- Badawy, M.E.I.; Rabea, E.I.; Taktak, N.E.M.; El-Nouby, M.A.M. The antibacterial activity of chitosan products blended with monoterpenes and their biofilms against plant pathogenic bacteria. Hindawi Publ. Corp. Sci. 2016, 2016, 1796256. [Google Scholar] [CrossRef] [PubMed][Green Version]

| Wavenumber (cm−1) | Assignment |
|---|---|
| 3430 (pellet) 3370 (film) | –OH stretching |
| 2884 | C–H stretching |
| 1635 | Amide I |
| 1570 | Amide II |
| 1414 | –CH2 bending |
| 1250 | amino group |
| 900, 1020, and 1155 | Saccharide structures |
© 2017 by the authors. Licensee MDPI, Basel, Switzerland. This article is an open access article distributed under the terms and conditions of the Creative Commons Attribution (CC BY) license (http://creativecommons.org/licenses/by/4.0/).
Share and Cite
Fortunati, E.; Giovanale, G.; Luzi, F.; Mazzaglia, A.; Kenny, J.M.; Torre, L.; Balestra, G.M. Effective Postharvest Preservation of Kiwifruit and Romaine Lettuce with a Chitosan Hydrochloride Coating. Coatings 2017, 7, 196. https://doi.org/10.3390/coatings7110196
Fortunati E, Giovanale G, Luzi F, Mazzaglia A, Kenny JM, Torre L, Balestra GM. Effective Postharvest Preservation of Kiwifruit and Romaine Lettuce with a Chitosan Hydrochloride Coating. Coatings. 2017; 7(11):196. https://doi.org/10.3390/coatings7110196
Chicago/Turabian StyleFortunati, Elena, Geremia Giovanale, Francesca Luzi, Angelo Mazzaglia, Josè Maria Kenny, Luigi Torre, and Giorgio Mariano Balestra. 2017. "Effective Postharvest Preservation of Kiwifruit and Romaine Lettuce with a Chitosan Hydrochloride Coating" Coatings 7, no. 11: 196. https://doi.org/10.3390/coatings7110196
APA StyleFortunati, E., Giovanale, G., Luzi, F., Mazzaglia, A., Kenny, J. M., Torre, L., & Balestra, G. M. (2017). Effective Postharvest Preservation of Kiwifruit and Romaine Lettuce with a Chitosan Hydrochloride Coating. Coatings, 7(11), 196. https://doi.org/10.3390/coatings7110196

